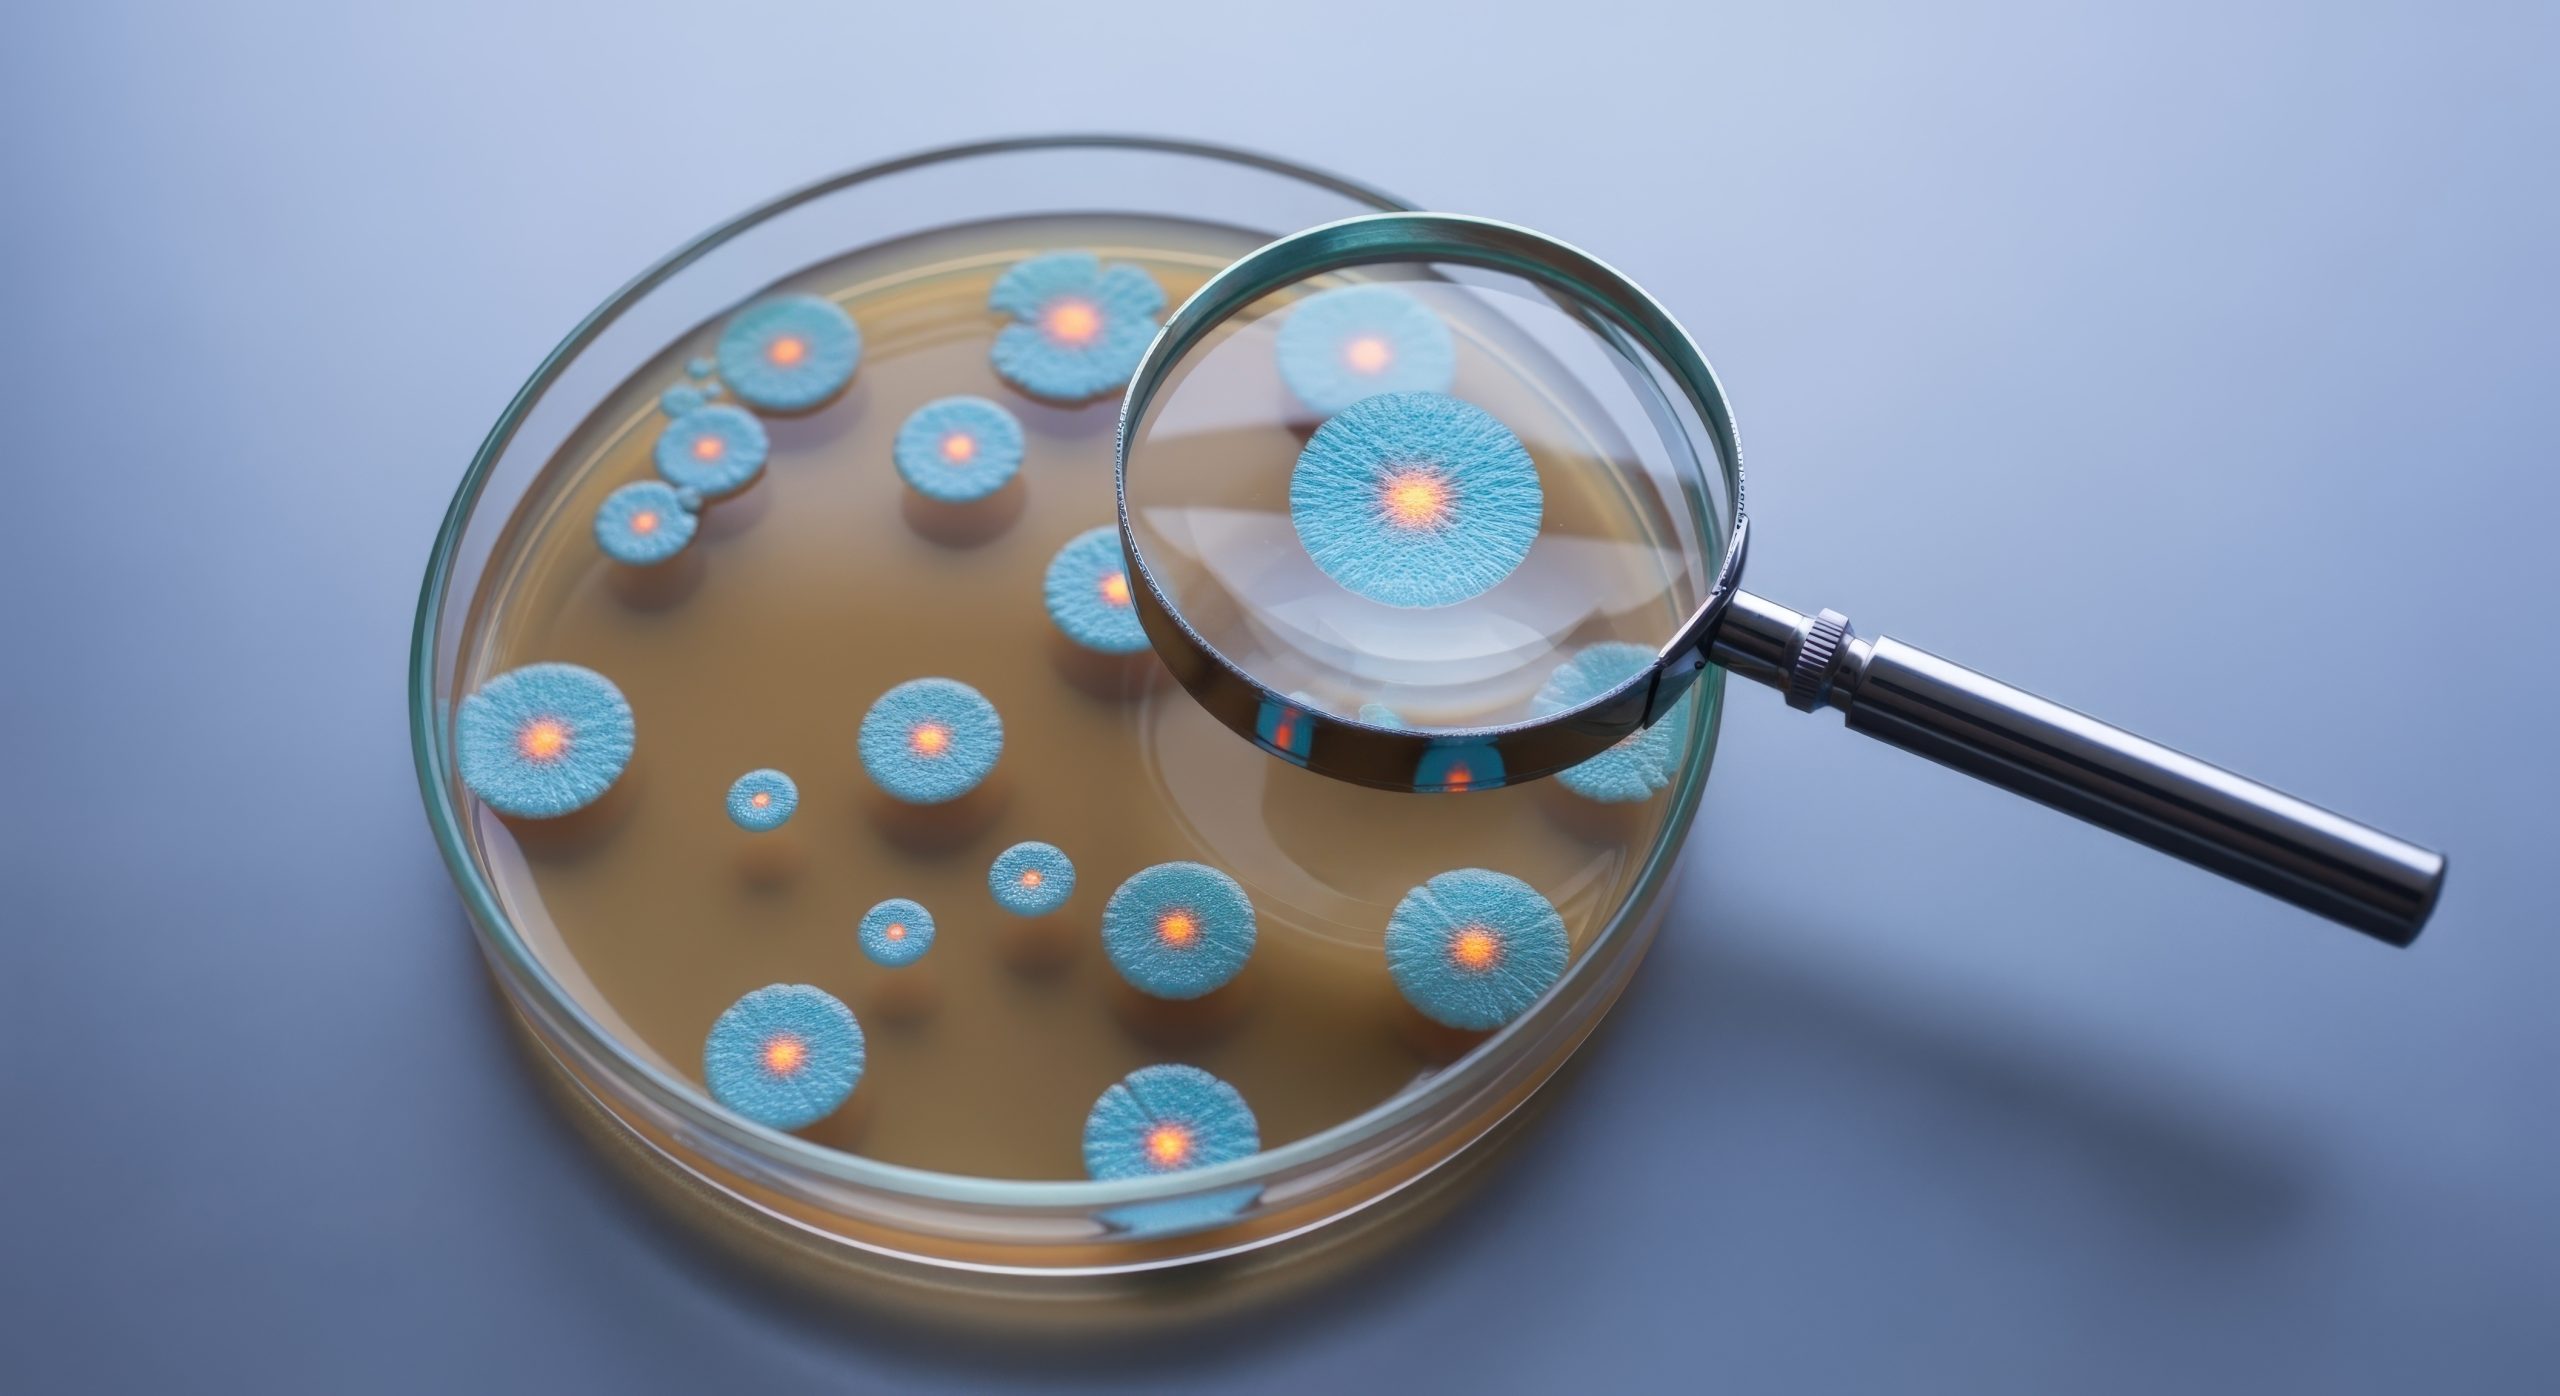

Bacterial contamination is one of the most common and most dangerous threats to private well water. Because wells draw water from underground aquifers, any breach, such as a cracked well casing, improper sealing, surface runoff, or nearby septic system issues, can allow harmful bacteria to enter the water supply. Our bacterial testing service focuses on detecting total coliform and E. coli, which are the primary indicators of microbiological contamination. Total coliforms signal that a pathway for contamination exists, while E. coli indicates the presence of fecal contamination and requires immediate corrective action.
Olympian Well Water Testing uses certified sampling methods to ensure accurate, legally defensible results. We follow strict chain-of-custody procedures and collect samples according to state and EPA guidelines. Because bacteria can multiply quickly and create health risks within hours, precision in sampling and laboratory handling is essential. Our process ensures that the results you receive are reliable and actionable.
If bacteria are detected, we provide clear recommendations on what to do next, most commonly shock chlorination or well disinfection.
Regular bacterial testing ensures the ongoing safety of your drinking water, especially for households with children, elderly family members, or anyone with weakened immune systems. We recommend testing at least once a year, and immediately after flooding, plumbing work, or any noticeable change in water taste, color, or odor. With Olympian Well Water Testing, you can confidently protect your household’s water supply all year round.

Metals and minerals occur naturally in groundwater, but at elevated levels they can impact health, plumbing systems, and the overall quality of your water. Our metals and minerals testing panel includes iron, manganese, and arsenic, three of the most significant and commonly elevated elements found in private wells. Iron and manganese can cause staining, metallic tastes, and sediment buildup, while arsenic poses serious long-term health risks and often goes unnoticed because it is colorless, odorless, and tasteless.
Olympian Well Water Testing uses advanced certified methods and laboratories to analyze your water for both total and dissolved concentrations of these minerals. This ensures a complete picture of what is present in your system and how it might be affecting your home. Elevated levels may indicate natural geological conditions, corrosion inside the well casing, or other environmental factors. Understanding the source is essential to determining the correct remediation method.
Once your results are ready, our team will review them with you in clear, understandable terms. If elevated iron or manganese is detected, we may recommend solutions such as filtration systems, sediment removal, or water softening equipment. If arsenic is present above recommended limits, we provide detailed guidance on treatment technologies such as adsorption or reverse osmosis. Because arsenic often requires long-term monitoring, we support clients with ongoing retesting schedules and system performance checks.
Testing for metals and minerals is essential for protecting both your household’s health and the longevity of your plumbing, appliances, and fixtures. Annual monitoring ensures that changes in groundwater conditions are detected early and treated effectively. With Olympian Well Water Testing, you receive accurate data, professional guidance, and long-term support for maintaining safe, high-quality well water.


Emerging contaminants like PFAS (Per- and Polyfluoroalkyl Substances) and VOCs (Volatile Organic Compounds) have become a growing concern for private well owners. PFAS are long-lasting industrial chemicals linked to serious health risks, including hormonal disruption and developmental effects. VOCs, including solvents, fuels, and industrial compounds, can enter groundwater from spills, runoff, or nearby commercial activities. Both categories of contaminants require highly sensitive laboratory methods for accurate detection.
Olympian Well Water Testing specializes in certified PFAS and VOC sampling. These contaminants cannot be reliably tested using consumer kits, as they require advanced laboratory instruments capable of detecting parts-per-trillion concentrations. Our team follows strict sampling protocols to prevent container contamination and ensure compliance with regulatory standards. This allows your results to be accurate, trustworthy, and suitable for long-term decisions.
After testing, we provide a clear explanation of the findings. PFAS and VOC results can be complex, with varying state guidelines and action levels. We simplify this information by outlining what levels are considered safe, what exceedances mean, and what treatment options may be available.
Because PFAS and VOC contamination is often linked to external factors such as industrial activity or environmental runoff, retesting is essential to ensure treatment systems continue working effectively. We help you establish a monitoring schedule and provide ongoing support based on changes in regulations, well conditions, or local environmental risks. Our goal is to give you clarity, safety, and complete confidence in your drinking water.

Maintaining a safe private well is an ongoing responsibility, not a one-time task. Our well water maintenance and retesting service is designed to help homeowners keep their systems functioning properly year-round. Over time, wells can be affected by seasonal changes, bacteria regrowth, mineral deposits, declining water levels, or damage to the well structure. Regular maintenance ensures your system remains clean, reliable, and efficient.
Retesting is an essential part of maintaining water quality. Even wells that previously tested clean can develop problems due to weather events, changes in groundwater conditions, or aging infrastructure. We recommend annual testing for bacteria, metals, and nitrates, and a customized schedule for more complex contaminants such as PFAS and VOCs. Our team keeps records of your past results, allowing us to track changes and identify patterns that may require corrective action.
If issues are detected during maintenance or retesting, we provide clear next steps, whether it’s shock chlorination, installing filtration systems, repairing well components, or conducting follow-up sampling. Our goal is to give homeowners peace of mind through reliable, professional support. With Olympian Well Water Testing, maintaining your well is simple, straightforward, and fully guided by experts who understand the unique testing needs of private water systems.
